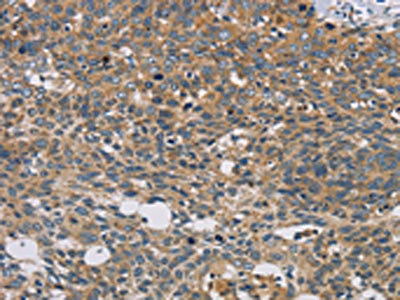

STAT4 Antibody
-
中文名稱:STAT4兔多克隆抗體
-
貨號:CSB-PA130463
-
規格:¥1100
-
圖片:
-
The image on the left is immunohistochemistry of paraffin-embedded Human cervical cancer tissue using CSB-PA130463(STAT4 Antibody) at dilution 1/30, on the right is treated with fusion protein. (Original magnification: ×200)
-
The image on the left is immunohistochemistry of paraffin-embedded Human thyroid cancer tissue using CSB-PA130463(STAT4 Antibody) at dilution 1/30, on the right is treated with fusion protein. (Original magnification: ×200)
-
-
其他:
產品詳情
-
產品描述:
The fusion protein of human STAT4 is used to immunized rabbits to generate the anti-STAT4 antibody. The resulting antibody is a polyclonal antibody and occurs as an unconjugated IgG. It was affinity-purified from rabbit antiserum through affinity-chromatography using epitope-specific immunogen. And it shows reactivity with human and mouse STAT4 protein. Upon activation by cytokines such as IL-12, type I interferons, and IL-23, the STAT4 protein increases the activity of genes that help T-cells mature into Th1 cells. Th1 cells further produce specific cytokines and stimulate other immune cells to get rid of foreign pathogens in the cell. This STAT4 antibody has been quality tested in ELISA and IHC applications.
-
Uniprot No.:
-
基因名:
-
別名:Signal transducer and activator of transcription 4 antibody; SLEB11 antibody; STAT4 antibody; STAT4_HUMAN antibody
-
宿主:Rabbit
-
反應種屬:Human,Mouse
-
免疫原:Fusion protein of Human STAT4
-
免疫原種屬:Homo sapiens (Human)
-
標記方式:Non-conjugated
-
抗體亞型:IgG
-
純化方式:Antigen affinity purification
-
濃度:It differs from different batches. Please contact us to confirm it.
-
保存緩沖液:-20°C, pH7.4 PBS, 0.05% NaN3, 40% Glycerol
-
產品提供形式:Liquid
-
應用范圍:ELISA,IHC
-
推薦稀釋比:
Application Recommended Dilution ELISA 1:1000-1:3000 IHC 1:50-1:200 -
Protocols:
-
儲存條件:Upon receipt, store at -20°C or -80°C. Avoid repeated freeze.
-
貨期:Basically, we can dispatch the products out in 1-3 working days after receiving your orders. Delivery time maybe differs from different purchasing way or location, please kindly consult your local distributors for specific delivery time.
-
用途:For Research Use Only. Not for use in diagnostic or therapeutic procedures.
相關產品
靶點詳情
-
功能:Carries out a dual signal transduction and activation of transcription. Involved in IL12 signaling.
-
基因功能參考文獻:
- the present study postulates that the genetic variation of the transcription factor GATA3, not STAT4, is associated with the risk of type 2 diabetes in the Bangladeshi population. PMID: 30044774
- Lack of association of rs7574865 and rs7601754 SNPs in STAT4 gene with susceptibility to JSLE in Iranian population, despite their association with the risk of adult SLE in the same population, implicates on difference of genetic background of JSLE and SLE. PMID: 29276866
- No significant associations between STAT4 variant and serum neopterin or disease activity parameters were identified. The study confirmed the association of STAT4 rs7574865 polymorphism with rheumatoid arthritis and was the first to indicate an association with rheumatoid factor and anti-cyclic citrullinated peptide antibodies positivity. PMID: 28424905
- 5 STAT4 SNPs were tested in 233 patients with established NMOSD and 492 healthy controls. Allelic, additive, dominant, and recessive models identified associations with NMOSD. Minor alleles of 4 STAT4 SNPs exhibited significant association with increased risk of NMOSD: rs7574865 T; rs10181656 G; rs10168266 T; and rs13426947 A in all models. rs7601754 G displayed a protective effect against NMOSD. PMID: 28852993
- data demonstrate that STAT4 plays a role in enabling the normal and timely division of cells undergoing mitosis PMID: 28516569
- Genome-wide association study identified a locus in STAT4, rs13390936, associated with nontyphoidal Salmonella bacteremia. PMID: 29523850
- Neither alleles nor genotypes of rs7601754 SNP of STAT4 gene demonstrated associations with juvenile rheumatoid arthritis (JRA). We recognize that gene variants of STAT4 did not affect JRA susceptibility in an Iranian population. PMID: 28524764
- STAT4 is a novel transcriptional regulator of p66Shc in normal and chronic lymphocytic leukemia B cells PMID: 27494881
- IL13 AA of rs20541 and STAT4 TT of rs925847 are potential genomic biomarkers for predicting lower pulmonary function. The administration of high-dose ICSs to asthmatic patients with genetic variants of IL13 AA may inhibit the advancement of airway remodelling. The genetic variants of STAT4 TT did not respond to high-dose ICSs. PMID: 26765219
- STAT4 mRNA expression was significantly correlated with IFNG mRNA expression. PMID: 29187449
- findings demonstrate that variants in STAT4 play a critical role in HBV infection and clearance in the Chinese Han population. PMID: 27444301
- STAT4 rs7574865G/T polymorphism is associated with rheumatoid arthritis and systemic lupus erythematosus in Mexican women PMID: 27178308
- STAT4_rs7574865 TT was associated with the presence of actively inflamed joints and extra-articular damage in patients with Juvenile Idiopathic Arthritis. PMID: 28145159
- Results found that activated STAT4 was overexpressed in epithelial cells of ovarian cancer and provide evidence that it promotes ovarian cancer metastasis via tumor-derived Wnt7a-induced activation of cancer-associated fibroblasts. PMID: 28114283
- STAT4 rs7574865 gene polymorphism is associated with the susceptibility of primary biliary cirrhosis in the Han population of Jiangsu province. PMID: 28395724
- The findings results confirm the important role of STAT4 gene in the predisposition to Systemic sclerosis and its phenotypes, such as the presence of Interstitial Lung disease , cardiac injury , and seropositivity for anti-topoisomerase I antibodies in the Russian population. PMID: 28631694
- results show specific and dominant contribution of STAT4 in the hematopoietic compartment to metabolic health and inflammation in diet-induced obesity. PMID: 28400678
- reported that SNPs in STAT4, PTPN2, PSORS1C1, and TRAF3IP2 are associated with response to TNF-i treatment in RA patients; however, these findings should be validated in a larger population PMID: 28107378
- This is the first demonstration of STAT4 acting as a transcriptional repressor in response to IFN-alpha/beta signaling and highlights the unique activity of this cytokine to acutely block the expression of an inflammatory cytokine in human T cells. PMID: 26990433
- A higher risk to develop RA was observed for rs7574865 in the STAT-4 gene, while the rs1800872 in the IL-10 gene showed a protective effect. PMID: 27342690
- STAT4 rs7574865 polymorphism has a role in rheumatoid arthritis and disease activity, but not in anti-CCP antibody levels in a Mexican population PMID: 27234231
- this study shows that STAT4 single nucleotide polymorphism affects clinical outcomes of pediatric acute leukemia patients after hematopoietic stem cell transplant PMID: 27960128
- this study shows that STAT4 gene polymorphisms are associated with ankylosing spondylitis in Southwest China PMID: 27394003
- Our results for the first time showed a significant association between STAT4 rs7582694 alleles and genotypes and susceptibility to endometriosis in a population. PMID: 27235632
- we can conclude that STAT4-rs7574865 polymorphism is clearly associated with the risk of Rheumatoid Arthritis in the Western Algerian population PMID: 25351936
- The results demonstrated that STAT4 rs7574865 and IRF5 rs2004640G/T substitution are associated with a susceptibility to systemic sclerosis. PMID: 26712637
- Our findings indicate that although STAT4 and IFIH1 SNPs are not associated with T1D in a Brazilian population, they might play a role in susceptibility to T1D on a larger worldwide scale PMID: 26782418
- SNP rs7574865 in STAT4 might contribute to progression to Hepatocellular Carcinoma. PMID: 26745093
- Five SNPs (rs7574865 in STAT4, rs9267673 near C2, rs2647073 and rs3997872 near HLA-DRB1 and rs9275319 near HLA-DQ), were found to be significantly associated with the risk of HBV-related LC. PMID: 26538132
- There is a significant association between STAT4 rs7574865 polymorphism and IBD susceptibility in overall population. PMID: 26066297
- STAT4 protein genetic variation is a prognostic factor predicting the treatment with interferon-alpha therapy in chronic hepatitis B. PMID: 26704347
- the presence of the rs7574865 T allele enhances STAT4 mRNA transcription and protein expression PMID: 26569609
- STAT4 rs7574865 polymorphism may be associated with significantly reduced risk of HBV-induced HCC in Asian PMID: 25178516
- gene polymorphisms along with Ptpn22 polymorphism confers susceptibility to rheumatoid arthritis in all major ethnic groups. [meta-analysis] PMID: 25963842
- Significant association with alleles of two STAT4 markers and nominal association of Autoimmune Addison's disease with alleles at GATA3, is reported. PMID: 24614117
- our replication study showed that the rs7574865 in STAT4 and rs9275319 in HLA-DQ were not associated with CHB-related HCC in a Korean population. PMID: 25913043
- CCR1, KLRC4, IL12A-AS1, STAT4, and ERAP1 are bona fide susceptibility genes for Behcet's disease. PMID: 26097239
- STAT4 rs7574865 G/T and PTPN22 rs2488457 G/C polymorphisms as susceptibility factors for JIA PMID: 25781893
- STAT4 minor allele may be associated with the spontaneous clearance of HBV, whereas the major allele may be associated with the progress of the HBV-related liver disease. PMID: 25829184
- STAT4 may inhibit HCC development by modulating HCC cell proliferation. PMID: 25852285
- Review/Meta-analysis: STAT4 rs7574865 polymorphism confers susceptibility to rheumatoid arthritis in major ethnic groups. PMID: 24751105
- Evidence of a higher risk to develop pericarditis with STAT4 genotypes, and an association between HCP5 rs3099844 and anti-Ro/SSA antibodies in Italian systemic lupus erythematosus patients. PMID: 25369137
- STAT4 rs7574865 seems to be Tibetan specific in hepatitis B virus natural clearance. PMID: 25041342
- STAT4 rs7574865 seemed not to correlate with hepatitis B virus infection susceptibility or natural clearance; its role in hepatocellular carcinoma development seemed ambiguous PMID: 25365208
- Loss of STAT4 expression and associated switch to Th2 phenotype during Mycosis Fungoides progression may be driven via aberrant histone acetylation and/or upregulation of oncogenic miR-155 microRNA. PMID: 25486484
- Increased expression of STAT4 is positively correlated with the depth of invasion in colorectal cancer patients. PMID: 25864744
- This work reported the association of 14q32.11 (EFCAB11) with Hepatocellular carcinoma in Chinese Han population and revealed the genetic interaction between STAT4 (2q32.2-q32.3) and EFCAB11 (14q32.11) in Hepatocellular carcinoma. PMID: 25665738
- STAT4 rs7574865/rs10181656 polymorphisms increase the risk of autoimmune thyroid diseases in a Chinese population. PMID: 25019342
- Rheumatoid arthritis cases showed a significantly higher frequency of the STAT4 T allele carriage (GT+TT genotypes) compared to controls. PMID: 24979672
- STAT4 plays a crucial role in the function of innate and adaptive immune cells; dysregulated expression and aberrant activation of STAT4 is observed in many human autoimmune conditions. PMID: 24844303
顯示更多
收起更多
-
相關疾病:Systemic lupus erythematosus 11 (SLEB11); Rheumatoid arthritis (RA)
-
亞細胞定位:Cytoplasm. Nucleus. Note=Translocated into the nucleus in response to phosphorylation.
-
蛋白家族:Transcription factor STAT family
-
數據庫鏈接:
Most popular with customers
-
-
YWHAB Recombinant Monoclonal Antibody
Applications: ELISA, WB, IHC, IF, FC
Species Reactivity: Human, Mouse, Rat
-
Phospho-YAP1 (S127) Recombinant Monoclonal Antibody
Applications: ELISA, WB, IHC
Species Reactivity: Human
-
-
-
-
-